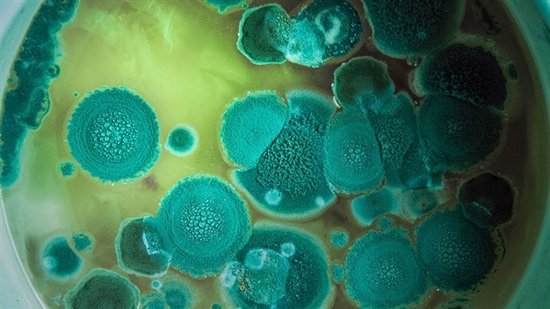

约翰·肯尼迪在1962年宣布美国将登陆月球,他表示这么做并非因为这容易,而是“因为它非常难”,然而他并不知道这究竟有多难。
尽管如此,阿波罗11号登月以及此后载人航天任务的成功均激发了各领域的太空探索者以同样的方式探索其他宇宙前哨。但对每一项新研究来说,到达火星和其他行星的旅程比预想的充满了更多风险。
从地球表面起飞并在另一颗行星着陆已经足够危险。然而,太空中的危险程度究竟有多大?《科学》杂志列举了火星和其他行星之旅中宇航员将面临的五大最严重威胁。

图1.很多宇航员梦想去往新世界,但这样的旅程却充满了威胁生命的危险。图片来源:NASA
宇宙辐射
通往另一个世界的途中,宇航员将会受到宇宙辐射的狂轰猛击:在空间中“嗖嗖”穿行的微小的高能原子碎片会损伤细胞和DNA。由于地球磁场的存在,地球人得以避免宇宙线的辐射,但是一名未经保护的飞往火星的宇航员仅单程就会受到0.3西弗特的辐射,这远低于8西弗特的致命辐射量或是1西弗特的致病辐射量,但研究人员认为这些辐射量(相当于24次X射线计算机断层成像的辐射量)足以对脑细胞和其他细胞造成无可逆转的损伤。
“在这一过程中,中枢神经系统是800磅的大猩猩。”加州大学尔湾分校辐射肿瘤学家 Charles Limoli说。在近日发表于《科学通报》的一项啮齿类动物研究中,Limoli表示宇宙射线会在通往其他行星的过程中对宇航员造成长期脑损伤,导致痴呆、记忆缺失、抑郁和决策能力下降等。
“对于那些要花费两三年时间往返于火星与地球之间的宇航员来说,这并不是好消息。”他说。但这个问题或许可以得到解决。包括Limoli在内的若干研究团队正在研究一种药物,它可以保护细胞和DNA免受损伤。另外,其他人也在设法研制能够让所有射线转移方向的盾牌。

图2。宇宙辐射、来自太阳的带电原子碎片和银河系外的超新星均会导致宇航员焦虑、抑郁并影响决策。图片来源:NASA
快憋疯了
如果你曾有过长途家庭旅行的经历,你可能会体验到一丝去往火星的滋味,只不过你老爹播放了太多ABBA乐队的歌曲,最终导致你逃离车厢。在长达1年无止无休的深空航行中,一次小口角对宇航员来说可能意味着生死。在今年发表的一项由NASA资助的长途太空飞行研究中,加州圣塔芭芭拉一家私人公司Anacapa Sciences的文化人类学家Jack Stuster写道,飞往国际空间站执行任务的宇航员的首个考虑就是与同行的人好好相处。
他们的日记整体上是积极向上的,但也反映了这个特点。“我觉得我实在想离开这里。”一名宇航员写道,“在如此逼仄的空间内与人长时间地生活,即便是那些平常根本不会惹恼你的事情过一段时间之后也会惹恼你……这会让任何人发疯。”
这还是从飞船的窗户上可以看得见地球时的情况。如果宇航员处于远离地球和目的地的宇宙空间时,事情会变得更加严酷,Stuster说。尽管这些感觉可以通过保持忙碌和对宇航员进行严格的心理监测加以限制,然而暴力甚至是暴动的“幽灵”将永远存在。

图3. NASA宇航员Scott Kelly在俄罗斯加加林宇航员培训中心的联盟号模拟器内。宇航员在通往另一颗星球的漫长旅途中需要在这样狭小的空间内和睦相处。
图片来源:Bill Ingalls/NASA
微重力
从YouTube视频中可以看到宇航员玩耍浮动水泡或是毫不费力地做空翻,似乎微重力让太空生活无比劲爆。然而在太空中,现实却严酷得多。重力缺失导致骨骼和肌肉退化,造成一系列生理问题。国际空间站的宇航员需要每天锻炼两小时才能阻止他们的肌肉流失,但骨密度流失却不可避免。
微重力还会通过其他不可预测的方式影响肌体。包括Scott Kelly在内的很多宇航员回到地球后都出现视力模糊的症状。据近日北美放射学会年会上的报告,其原因是脊髓液增加压迫视神经和眼球从而导致远视。在另一项研究中,科学家发现当国际空间站宇航员在太空中时,他们的脊柱肌肉(对于支撑和运动非常关键)显著萎缩——下降了19%。
这可能是超过一半国际空间站人员存在脊柱疼痛的原因,也可能是他们比地球居民椎间盘突出比例高出4倍的原因之一。那么,解决方法是什么呢?太空瑜伽!研究人员表示这或有助增加脊柱活动和强度。不过,他们究竟要做哪些瑜伽姿势尚待确定。
图4. 微重力让太空饮食变得有趣,但它还会导致肌萎缩。像美国宇航局的Karen Nyberg一样的宇航员必须每天锻炼两小时才能阻止在轨期间的肌肉流失。图片来源:NASA
太空病菌
从上世纪60年代起,人们就知道一些微生物可以在微重力、极端气温和辐射的危险太空环境中生存。考虑到人们尽最大努力清除飞船上的微生物常常以失败告终,宇航员接触这些潜在的病原生物体在所难免。现在,一项新研究也支持这一观点。
今年10月,研究人员发现通过空气传播的真菌烟曲霉菌在国际空间站可以像在地球上生长得一样好,这种病菌是最常见的人体侵入性真菌感染的原因。研究人员写道,如果烟曲霉菌可以在太空中很好地生存,那么很多其他致命病原体也同样可以。研究人员表示这个问题迫切需要更好的探测和清洁策略,从而避免将满满一飞船的宇航员送到深空的危险环境中,使他们被地球上的病原体杀死。

图5. 烟曲霉菌是导致人体产生侵入性真菌感染的最常见原因。这种在空气中滋生的微生物在国际空间站也可以很好地生存。
图片来源:Anna_Gavrylova
人为错误
人非常容易出错,在太空中的错误经常会酿成严重后果。科幻小说《火星救援》的作者Andy Weir就曾利用这一点组织了大量情节,描述陷入困境的宇航员如何专业地解决了数十个生死存亡问题。现实中的太空探索者并不总是那么幸运。以挑战者号和哥伦比亚号航天飞机为例,两者均因为机械故障而解体,均导致搭载航天飞机的7名航天员罹难。
挑战者号失事的罪魁祸首是O形环橡胶密封圈,故障使得密封圈不能在冷环境中正常密封,从而导致航天飞机在空中解体。哥伦比亚号则在重新返回时解体,原因是分离自机体的绝缘泡沫塑料隔热层刺破了飞船左翼前缘。在两起事故中,美国宇航局管理人员均知晓其中的机械问题,但却认为这些问题无伤大雅,因为它们过去从未对航天任务造成影响。
在长距离太空飞行中,神经可能会处于紧绷状态,辐射也可能导致不常见的焦虑、抑郁困扰,看到人为原因造成的错误并不奇怪,如紧急迫降、太空舱漏洞或甚至是缺少饮用水供给等。千方百计减少太空危险,从过去的错误中汲取教训,将有助于确保未来最安全地飞往火星和其他行星。如果运气再好一点,我们的宇航员最后也会像Weir笔下的探险者一样获得成功。

图6、中国北京航天飞行控制中心的技术人员在进行飞行任务控制,他们和宇航员携手工作,以确保任务顺利进行不出差错。图片来源:新华社

!评论内容需包含中文